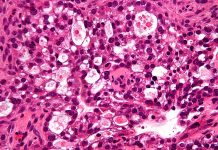
Leukaemia anti-cancer drug may work against rare ovarian cancer Leukaemia anti-cancer drug may work against rare ovarian cancer

22 new genetic risk factors for stroke have been identified
Researchers in Munich, Germany, have identified 22 new genetic risk factors for stroke, helping to create a new understanding of the underlying causes.
Stroke is...
Nightingale to analyse 40,000 blood samples to enhance Finnish healthcare
Nightingale Health is set to analyse 40,000 blood samples from the largest biobank in Finland, THL Biobank, to help bring personalised medicine to Finnish...
Fertility Tracker maximises fertility options
A leading healthcare and technology company has developed a new fertility tracker that will help couples struggling to reproduce identify the optimum time for...
New AI service to aid treatment of gestational diabetes
CleverHealth Network is launching its first development project in Finland, which takes the form of a digital service model based on artificial intelligence to...
Regular exercise throughout life slows down body’s ageing process
New research from the University of Birmingham and King’s College London, UK, has found that a lifetime of regular exercise slows the down the...
Brain alterations and cognitive impairment linked to air pollution
A new study in the Netherlands has discovered a link between residential air pollution exposure among school-age children and brain abnormalities and cognitive impairment.
The...
Defying the odds – my journey to becoming a Highly Cited Researcher
Professor Eun-Jung Park chronicles her path from a ‘young child from a poor family in South Korea’ to a celebrated scientist and Highly Cited...
Leukaemia anti-cancer drug may work against rare ovarian cancer
A study has found that an anti-cancer drug, ponatinib, which is used to fight leukaemia, has shown promise in tackling a rare and aggressive...
A promising new therapeutic approach to spinal cord injuries
Researchers at Karolinska Institutet, Sweden, have been able to improve functional recovery following spinal cord injuries in mice, paving the way for new therapeutic...
New classification suggests five different types of diabetes
Results of a Swedish study (ANDIS) have indicated that there are more than two types of diabetes, meaning the need for new and better...
Cambridge cancer research centre given prestigious designation
The Cancer Research UK Cambridge Centre has been named a comprehensive cancer centre of excellence by the European Academy of Cancer Sciences (EACS).
Cambridge is...
University of Denmark invests in secondary metabolites research
The University of Denmark (DTU) is to open a new Center of Excellence of Microbial Secondary Metabolites (CeMiSt), which will help identify why micro-organisms...
Brain’s natural painkilling system could be alternative to opioids
Researchers from the UK and Japan have discovered a way to use the brain’s natural painkilling system as an alternative to opioids for the...
First-of-its-kind breastfeeding research centre to open
The University of Zurich (UZH), Switzerland, is planning to increase its research in the child and youth development area by creating a new centre...
Is a DASH diet linked to reduced risk of depression?
According to a new study from Rush University Medical Center, US, Dietary Approaches to Stop Hypertension, or a DASH diet of vegetables, fruits and...
How effective is this ‘wonder drug’ for alcohol use disorders?
A new study by researchers from the University of Liverpool has demonstrated the ineffectiveness of a so-called ‘wonder drug’ used to treat alcohol use...
The fight against obesity and Type 2 diabetes
A collaboration between the University of Cambridge's Nanoscience Centre and MedImmune is taking great strides towards safer and more effective treatment of obesity and...
Personalising cancer treatment with lab-grown mini tumours
A major new study on bowel and stomach tumours has reported that replicating a patient’s tumour in the lab to create mini tumours and...
Newly adapted HIV test will help diagnose Zika virus
Researchers from New York University (NYU), US, are developing a test for Zika virus that uses saliva to identify diagnostic markers of the virus...
Do surgery and anaesthesia cause memory issues?
A new study has suggested that patients who have recently had surgery and anaesthesia may score slightly lower on certain memory tests.
To understand the...